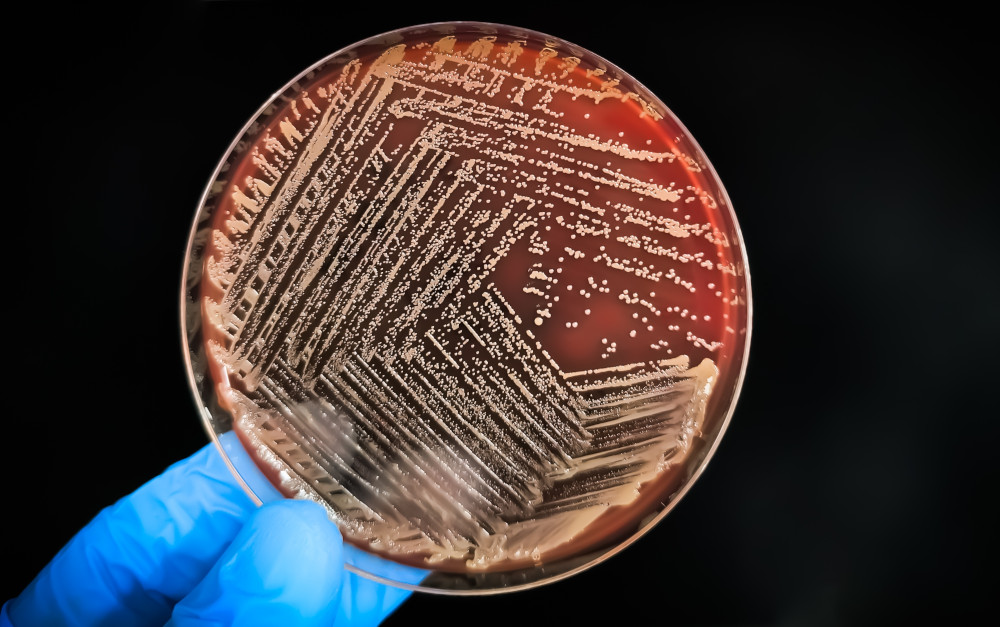
lab agar plate

What is fetal bovine serum and should it be used?
The commercial production of fetal bovine serum starts with the collection of blood from fetal calves at licensed abattoirs. Because the blood of unborn calves has only been exposed to their mother’s blood coming to them across the placenta (which filters out most bacteria and viruses), fetal blood is free of micro-organisms, and this makes it ideal for use by laboratories for different purposes. RSPCA strongly advocates for the use of non-animal derived alternatives to the use of fetal bovine serum. Where a synthetic serum or another non-animal derived alternative exists, these should be used rather than an animal-derived product.
What is fetal bovine serum?
Fetal bovine serum (also known as fetal calf serum) is a biological product obtained from the blood of fetal (unborn) calves. Serum is the component of blood left after the red blood cells have been removed (the blood is allowed to clot and then spun at high speed which separates the serum allowing it to be collected). Depending on the size of the fetus, up to about half a litre of raw serum may be produced from the blood collected from one fetal calf. Because fetal bovine serum promotes cell growth and cell proliferation, it has many applications including as an additive in growth media for cell and tissue culture, as an additive in specific diluting agents, in the production of vaccines, as a stabiliser in some protein binders, and in the production of cultured meat.
Bovine serum may also be obtained from blood collected from newborn calves, older calves, and adult cows, as well as from donor herds raised specifically for the collection of blood to produce serum. Other animals used in the production of serum include chickens, goats, horses, pigs, rabbits, and sheep. On-farm blood collection from perinatal conscious calves – as distinct from collection from dead fetal calves at licensed abattoirs as described here - should not be undertaken due to the significant risk to animal welfare.
Under what conditions should fetal blood be collected?
The RSPCA believes that whilst the practice of taking blood from bovine fetal calves to produce fetal bovine serum continues, that fetal blood should only be collected at licensed export abattoirs unless domestic abattoirs are able to demonstrate to the regulating authority that their animal welfare standards are at least equivalent. Animal welfare at export abattoirs is managed and monitored through the export meat industry’s animal welfare standards and compliance system; there is a requirement for training and competency assessment; and there is a veterinarian in attendance. These factors combined present the basis from which the collection of bovine fetal blood can be carried out humanely.
The abattoir collecting fetal blood is required to be specifically licensed for this activity by the regulating authority and the RSPCA believes that fetal blood collection should also be overseen by the abattoir’s registered veterinarian who must be familiar with the procedure and technique.
The RSPCA believes that bovine fetal blood collection should only be carried out by a competent operator trained in the technique. Written procedures describing bovine fetal blood collection should be in place and adhered to at the abattoir and include clear and detailed descriptions of the timing and technique of slaughter and bleed-out of the mother, removal of the uterus, removal of the fetal calf from the uterus, confirmation of fetal calf death, euthanasia of the fetal calf (if required), and blood collection.
The RSPCA believes that a video surveillance system should be installed and operational at all times to allow a clear view of the procedure taking place and to allow monitoring and auditing of real-time and stored footage by authorised officers to ensure the correct technique is maintained and prompt action is taken where any problems are identified.
The RSPCA believes that the number of pregnant cattle slaughtered and the number of fetal calves used for the collection of blood should be recorded by the abattoir and provided to the regulating authority which should then publish these statistics annually.
It should be noted that prior to arriving at the abattoir, pregnant cattle will have undergone a period of transport which is stressful for farmed animals and particularly when transporting pregnant animals in late gestation. Animal welfare issues can arise through separation of the animals from their familiar environments and social groups, forced interaction with unfamiliar animals, unfamiliar/poor handling by people, overcrowding, water and food deprivation, exposure to extremes of temperature and humidity, and novel experiences and situations. These negative impacts may also occur at the abattoir.
How is fetal blood collected?
Pregnant cattle may be sent to slaughter for several reasons including management (e.g., producer is unaware the animal is pregnant), health (e.g., mastitis, lameness, or feet problems), or economic (e.g., low milk or calf price (dairy cattle), cash-flow requirement). Pregnancy status may be unknown at time of arrival at the abattoir and, where an animal is found to be pregnant (i.e., at evisceration), only fetuses estimated to be five to six months of age or older are considered suitable for blood collection (smaller fetuses are rendered along with other animal by-products and transformed into usable materials). The collection of fetal blood from the fetuses of pregnant cows presented at slaughter, although a commercial activity, is therefore largely opportunistic. The RSPCA does not support the intentional impregnation and slaughter of pregnant cows for the primary purpose of collection of blood from fetal calves.
At evisceration of the dam, the uterus is not removed until 20-30 minutes after bleeding out of the dam commenced. The uterus is then removed carefully to ensure it remains intact and the fetal calf is not exposed to oxygen. The fetal calf is then removed from the uterus (either in its entirety or partly exposed) within another 5 to 10 minutes.
Following removal from the uterus, the fetal calf should be checked to confirm death and blood collection then commences. If there is any doubt that the fetal calf is dead when removed from the uterus, the calf should be immediately euthanased.
Fetal calves must never be attempted to be revived. Serious welfare concerns may arise if fetal calves are revived including impaired brain function due to lack of oxygen, breathing difficulty, and increased risk of infections due to fetal immaturity.
Is the fetal calf conscious?
Consciousness, or awareness, and thus suffering of the fetus is related to brain activity which, in turn, is related to blood oxygen supply. Following death of the dam, the unconscious fetus may respond to touch by moving, but is not capable of suffering or feeling pain because of the low blood oxygen level in the uterus that maintains unconsciousness. The fetus must be prevented from inflating their lungs and breathing air at any stage after entire or part removal from the uterus and thus becoming conscious. If the fetus can inflate their lungs and breathe, blood oxygen levels will rise, the brain will be provided with oxygen, and the calf will become conscious and have the capacity to suffer.
Evisceration of the dam usually occurs between 20 to 30 minutes after the dam’s neck or chest cut (bleed-out). At this point, the death of the dam and associated absence of oxygen supply to the fetus will mean that the fetal calf is highly likely to be dead. Five minutes after the dam’s neck or chest cut, the fetal calf will be unconscious within the uterus although a heartbeat and other movements may still occur. Fifteen to 20 minutes after bleed-out of the dam, lack of oxygen to the fetal calf will have resulted in significant brain damage and likely death of the fetus. After 30 minutes, the fetal calf is expected to be dead.
Are there alternatives to collecting blood from animals?
Fetal bovine serum is manufactured from blood collected from multiple fetal calves. A key disadvantage of this process is that the serum varies from batch to batch thus hindering reproducibility and reliability for research purposes. This adds to the reasons to replace fetal bovine serum (and the collection of fetal blood) with alternative, non-animal-derived product.
RSPCA strongly supports the ethical and humane research principles (known as the 3Rs) to replace the use of animals with alternative techniques, reduce the number of animals used, and refine procedures to improve the welfare of animals in research.
Alternative additives/supplements for cell culture media that are entirely free of animal-derived product are available (see e.g. Fetal Calf Serum-free Database). The RSPCA supports increased uptake of and urges greater investment into the development of non-animal alternatives.
Bibliography
American Veterinary Medical Association (AVMA) (2024) AVMA guidelines for the humane slaughter of animals: 2024 edition. Accessed 25 March 2025
Bajramovic JJ (2024) Concerns for the use of fetal calf serum (FCS). Accessed 25 March 2025
Campbell MLH, Mellor DJ, Sandøe P (2014) How should the welfare of fetal and neurologically immature postnatal animals be protected? Anim Welfare 23(4):369-379
European Food Safety Authority (EFSA) (2017) Animal welfare aspects in respect of the slaughter or killing of pregnant livestock animals (cattle, pigs, sheep, goats, horses). EFSA Journal 15(5):4782
Lee DY, Lee SY, Yun SH, Jeong JW, Kim JH, Kim HW, Choi JS, Kim G-D, Joo ST, Choi I, Hur SJ (2022) Review of the current research on fetal bovine serum and the development of cultured meat. Food Sci Anim Resour 42(5):775-799
Lee DY, Piñero Majó M, Han D, Choi Y, Kim JS, Park J, Yun SH, Mariano Jr E, Lee J, Hur SJ (2024) Development of fetal bovine serum substitute derived from egg for muscle satellite cell culture: A preliminary study. Future Foods 10:100396
Manteca Vilanova X, Beaver B, Uldahl M, Turner PV (2021) Recommendations for ensuring good welfare of horses used for industrial blood, serum, or urine production. Animals 11(5):1466
Mellor DJ (2003) Guidelines for the humane slaughter of the fetuses of pregnant ruminants. Surveillance 30(3):26-28
Mellor DJ (2020) Galloping colts, fetal feelings, and reassuring regulations: putting animal-welfare science into practice. J Vet Med Educ 37(1):94-100
MINTRAC (2011) MTMP2176C Process slink by-products. Training and assessment support materials. MTM11 Australian Meat Industry Training Package. Certificate II Meat Processing. National Meat Industry Training Advisory Council
Thermo Fisher Scientific Inc (n.d.) Other bovine sera: Newborn calf serum, bovine calf serum, and adult bovine serum. Accessed 25 March 2025
Thermo Fisher Scientific Inc (n.d.) The basics of fetal bovine serum use in cell culture. Accessed 2 April 2025
Utrecht University (n.d.) Fetal calf serum-free database. Accessed 25 March 2025
van der Valk J, Bieback K, Buta C, Cochrane B, Dirks WG, Fu J, Hickman JJ, Hohensee C, Kolar R, Liebsch M, Pistollato F, Schulz M, Thieme D, Weber T, Wiest J, Winkler S, Gstraunthaler G (2017) Consensus Report: Fetal Bovine Serum (FBS): Past – Present – Future. ALTEX Online first
van der Valk J (2022) Fetal bovine serum—a cell culture dilemma. Science 375(6577):143-144
Weber T, Wiest J, Oredsson S, Bieback K (2022) Case studies exemplifying the transition to animal component-free cell culture. Alts to Lab Ans 50(5):330-338
World Organisation for Animal Health (WOAH) (2024) Terrestrial Animal Health Code. Chapter 7.5 ‘Animal welfare during slaughter’, article 7.5.21. Accessed 25 March 2025
Was this article helpful?
This work is licensed under a Creative Commons Attribution-NonCommercial-NoDerivatives 4.0 International License.


